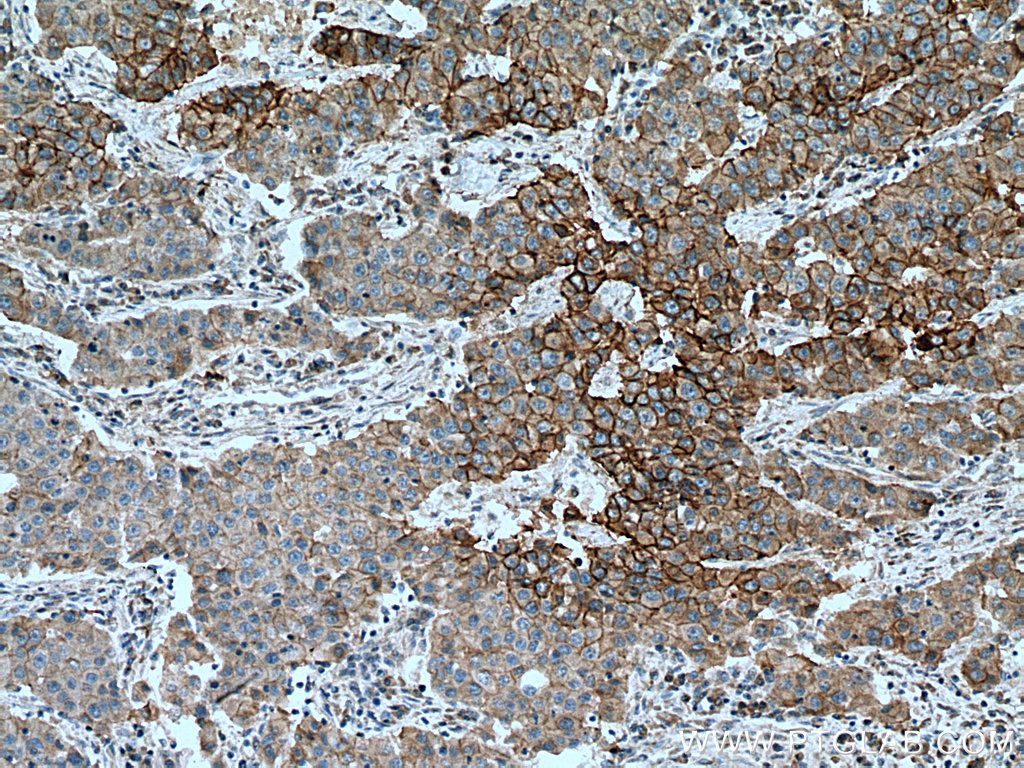
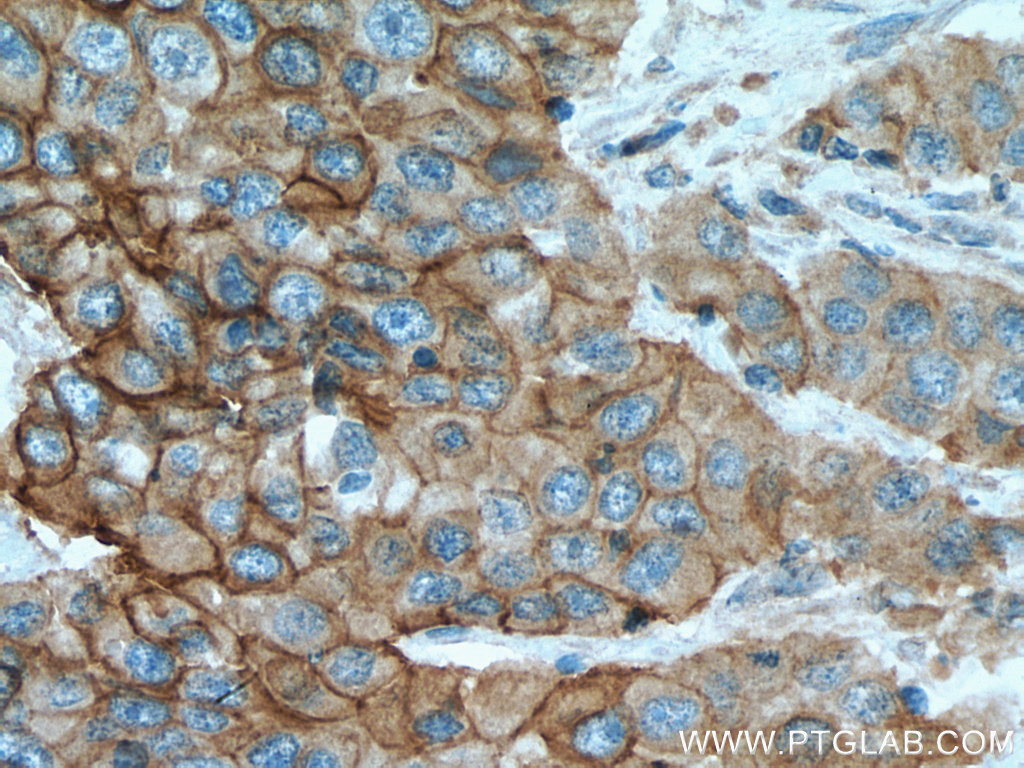
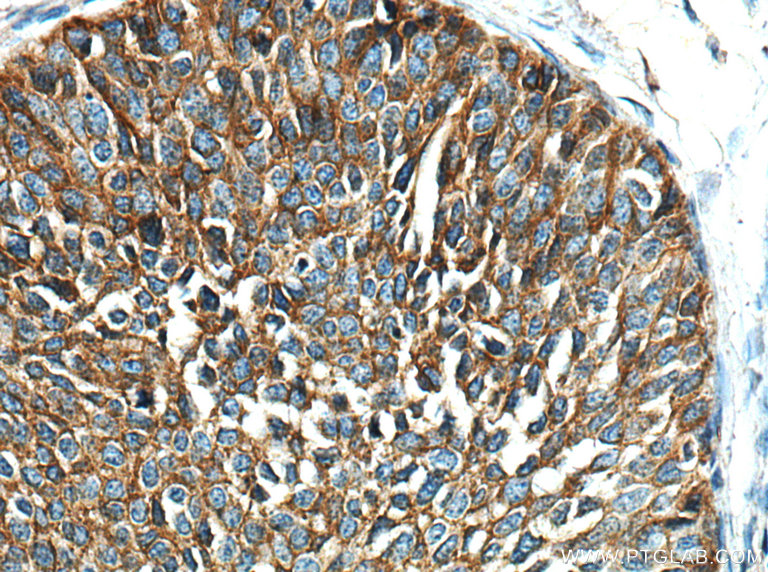
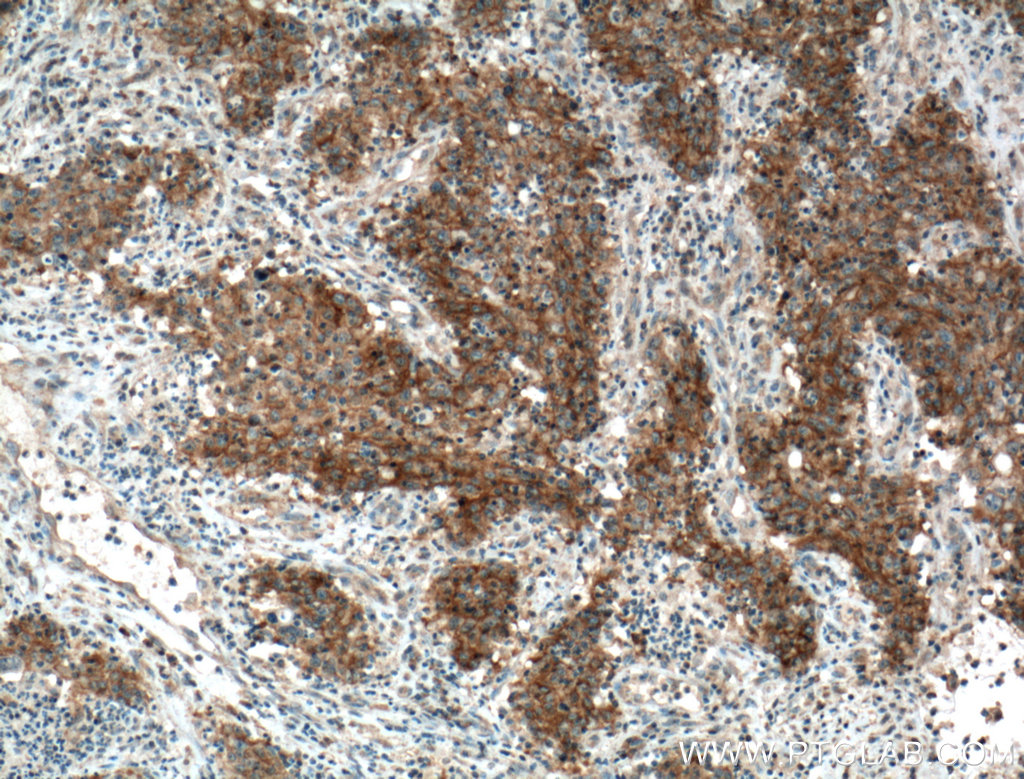
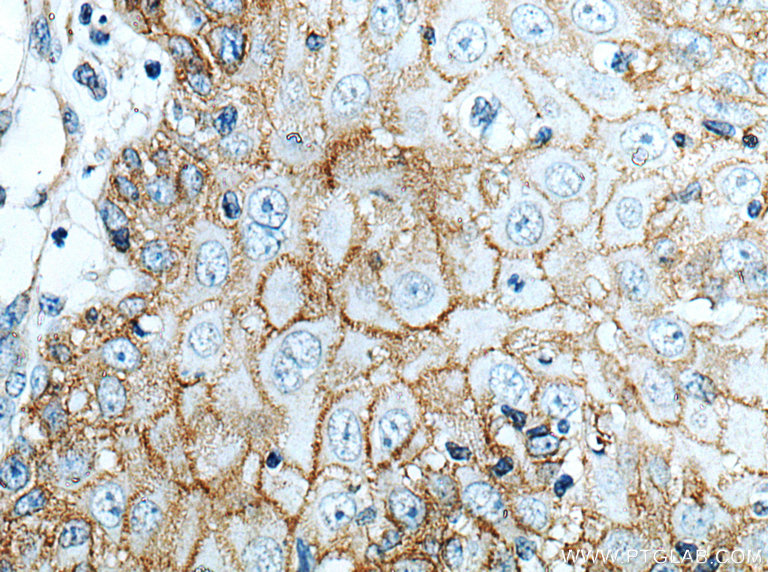

验证数据展示
经过测试的应用
| Positive WB detected in | A431 cells, EC109 cells, A549 cells, HeLa cells, HepG2 cells, LNCaP cells, PC-3 cells, SKOV-3 cells, MDA-MB-468 cells, MDA-MB-231 cells, PC-3 clles |
| Positive IHC detected in | human tonsillitis tissue, human breast cancer tissue, human cervical cancer tissue, human colon cancer tissue, human gliomas tissue, human lung cancer tissue, human placenta tissue, human skin cancer tissue Note: suggested antigen retrieval with TE buffer pH 9.0; (*) Alternatively, antigen retrieval may be performed with citrate buffer pH 6.0 |
推荐稀释比
| 应用 | 推荐稀释比 |
|---|---|
| Western Blot (WB) | WB : 1:5000-1:50000 |
| Immunohistochemistry (IHC) | IHC : 1:2000-1:8000 |
| It is recommended that this reagent should be titrated in each testing system to obtain optimal results. | |
| Sample-dependent, Check data in validation data gallery. | |
产品信息
66455-1-Ig targets EGFR in WB, IHC, IF, ELISA applications and shows reactivity with human samples.
| 经测试应用 | WB, IHC, ELISA Application Description |
| 文献引用应用 | WB, IHC, IF |
| 经测试反应性 | human |
| 文献引用反应性 | human |
| 免疫原 |
CatNo: Ag24947 Product name: Recombinant human EGFR protein Source: e coli.-derived, PET30a Tag: 6*His Domain: 291-534 aa of BC094761 Sequence: VCNGIGIGEFKDSLSINATNIKHFKNCTSISGDLHILPVAFRGDSFTHTPPLDPQELDILKTVKEITGFLLIQAWPENRTDLHAFENLEIIRGRTKQHGQFSLAVVSLNITSLGLRSLKEISDGDVIISGNKNLCYANTINWKKLFGTSGQKTKIISNRGENSCKATGQVCHALCSPEGCWGPEPRDCVSCRNVSRGRECVDKCNLLEGEPREFVENSECIQCHPECLPQAMNITCTGRGPDNC 种属同源性预测 |
| 宿主/亚型 | Mouse / IgG1 |
| 抗体类别 | Monoclonal |
| 产品类型 | Antibody |
| 全称 | epidermal growth factor receptor (erythroblastic leukemia viral (v-erb-b) oncogene homolog, avian) |
| 别名 | 2A2H10, EGF R, EGF Receptor , Epidermal growth factor receptor, Proto-oncogene c-ErbB-1 |
| 计算分子量 | 1210 aa, 134 kDa |
| 观测分子量 | 145-180 kDa |
| GenBank蛋白编号 | BC094761 |
| 基因名称 | EGFR |
| Gene ID (NCBI) | 1956 |
| RRID | AB_2881824 |
| 偶联类型 | Unconjugated |
| 形式 | Liquid |
| 纯化方式 | Protein G purification |
| UNIPROT ID | P00533 |
| 储存缓冲液 | PBS with 0.02% sodium azide and 50% glycerol, pH 7.3. |
| 储存条件 | Store at -20°C. Stable for one year after shipment. Aliquoting is unnecessary for -20oC storage. |
背景介绍
EGFR, also named as ERBB1, is a cell-surface receptor for members of the epidermal growth factor family (EGF-family) of extracellular protein ligands. Binding of the protein to a ligand induces receptor dimerization and tyrosine autophosphorylation and leads to cell proliferation. The gene resides on chromosome 7p12, encoding a 170 kDa membrane-associated glycoprotein. Recent studies have shown EGFR plays a critical role in cancer development and progression, including cell proliferation, apoptosis, angiogenesis, and metastatic spread. Mutations in this gene are associated with lung cancer.
实验方案
| Product Specific Protocols | |
|---|---|
| IHC protocol for EGFR antibody 66455-1-Ig | Download protocol |
| WB protocol for EGFR antibody 66455-1-Ig | Download protocol |
| Standard Protocols | |
|---|---|
| Click here to view our Standard Protocols |
发表文章
| Species | Application | Title |
|---|---|---|
Nat Commun EGFR core fucosylation, induced by hepatitis C virus, promotes TRIM40-mediated-RIG-I ubiquitination and suppresses interferon-I antiviral defenses | ||
Mol Cell N7-Methylguanosine tRNA modification enhances oncogenic mRNA translation and promotes intrahepatic cholangiocarcinoma progression.
| ||
Cancer Res Inhibition of EGFR Overcomes Acquired Lenvatinib Resistance Driven by STAT3-ABCB1 Signaling in Hepatocellular Carcinoma | ||
Pharmacol Res Upregulation of CSNK1A1 induced by ITGB5 confers to hepatocellular carcinoma resistance to sorafenib in vivo by disrupting the EPS15/EGFR complex | ||
Cell Death Dis Neurokinin-1 receptor promotes non-small cell lung cancer progression through transactivation of EGFR. |